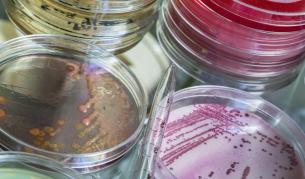
virus

Наука и техника

6 реалистични края на света заради космически събития
05.04.2017
Процеси, които са отвъд възможностите на човечеството, могат да решат неговата съдба

Брекзит всъщност се е случил преди 450 хил. години
05.04.2017
Учени изясниха как са се формирали Британските острови

Софтуер ще открива рака преди появата на симптоми
03.04.2017
Чрез изследване на ДНК в кръвта, програмата ще показва наличието на тумор и неговото местоположение.
Лек от IX в. убива устойчивите на антибиотици бактерии
31.03.2017
Списание "Ню сайънтист" разказва как медиците са успели да пресъздадат и да проверят чрез експеримент древно лекарство

Дълбоко учене: крачка отвъд машинното учене
28.03.2017
Регионалният директор на глобалната технологична компания RTB House е един от лекторите на IAB Forum 2017

Учени изобретиха изкуствена кожа със слънчево захранване
28.03.2017
Това нововъведение цели да замести реалистичния външен вид с нещо по-добро – функционалност

Срокът за E-volution Awards 2017 е удължен
28.03.2017
В конкурса могат да се включат всички онлайн бизнеси или компании

26 прогнози за бъдещето на Пламен Русев
24.03.2017
На съвместна пресконференция в градината на “Кристал”, Пламен Русев и Йорданка Фандъкова откриха изложбата “26 прогнози за бъдещето на...

Телескопът "Хъбъл" засне "бягаща" черна дупка
24.03.2017
Учени за пръв път наблюдават черна дупка, която е "изгонена" от галактиката си

Какво е бъдещето на онлайн търговията
23.03.2017
Отговорът се търси на бизнес форума „МySuccess in Retail 3.0

Webit награждава най-иновативните проекти
21.03.2017
Webit AWARDS ще отличи най-добрите дигитални проекти, иноватори и интегратори на технологични решения в България, Централна и Източна Европа

Черепът и ходенето на два крака са еволюирали заедно
21.03.2017
Новото изследване разкрива, че връзката между ходенето на два крака и изместения напред в черепа форамен магнум не е изолиран случай...

Търсят се най-добрите онлайн търговци
20.03.2017
До 25 март се събират кандидатури за eCommAwards 2016

9 месеца по-късно: Мъжът, на когото присадиха ново лице
20.03.2017
Андрю Санднес вече може да се храни, диша и говори

БГ компания с международни иновации в онлайн търговията
20.03.2017
Днес ви представяме Любомир Чолаков, който е председател на журито на eCommAwards

Шакил О'Нийл е убеден, че Земята е плоска
20.03.2017







